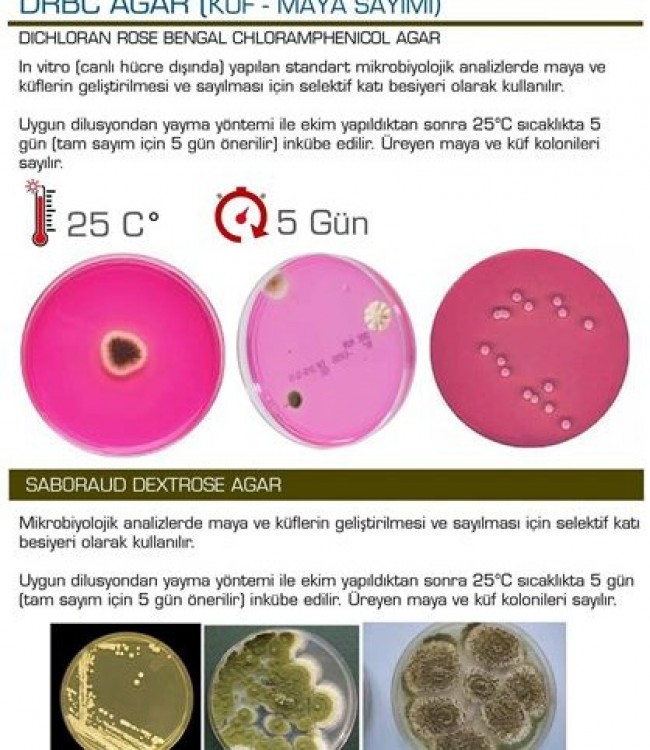
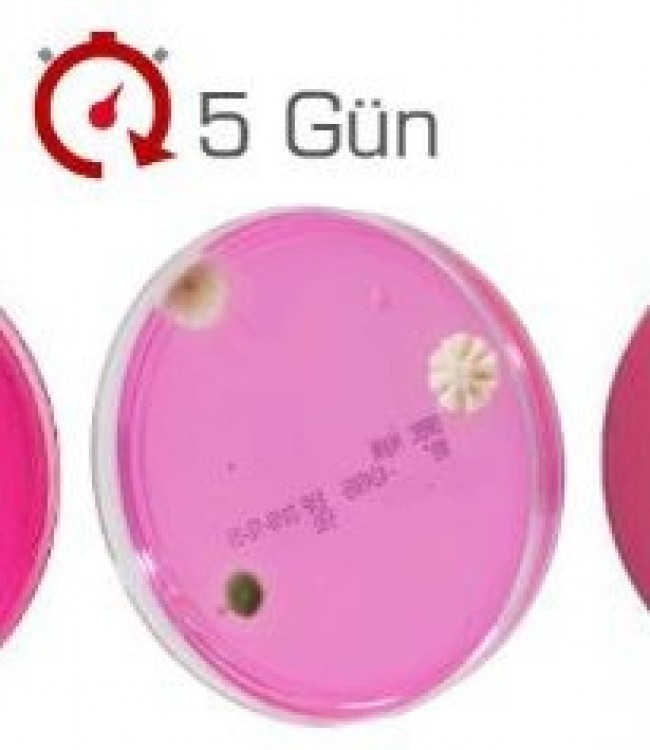

VRBG Agar (Enterobacteriaceae)
VRBG AGAR (ENTERDBACTERIACEAE)
Violet Red Bile Glucose (VRBG) olarak da bilinir.
Uygun dilusyondan yayma yöntemi ile ekimin ardından 35-37 C'de 24-48 saat
süren inkübasyondan sonra 1-2 mm çapında kırmızımsı bir presipitat zonu ile
çevrili kırmızı koloniler Enterobacteriaceae familyası üyeleri olarak sayılır.